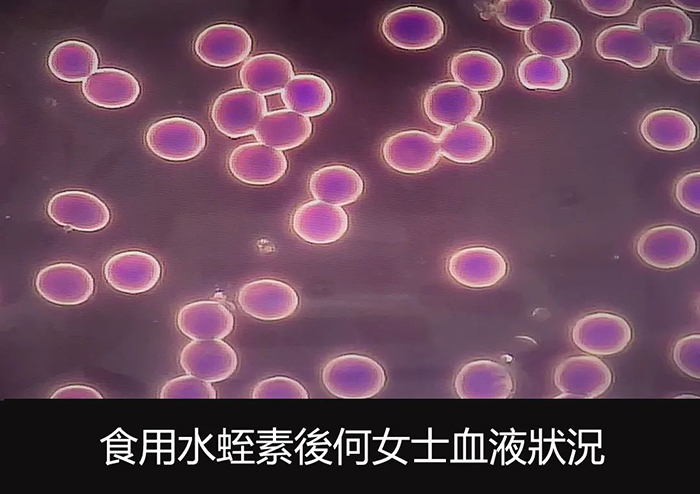
8.jpg

甲状腺丨6瓶金康道夫天然水蛭素,甲状腺肿瘤消除
2024-04-19 分类: 行业资讯 作者: 金康道夫官网
何女士,在医院查出一颗甲状腺良性肿瘤,平时触碰到会感觉刺痛,颈部有较强不适。 服用金康道夫天然水蛭素约一个月,她惊喜发现,甲状腺肿瘤明显缩小,已经感觉不到其存在,碰触该区域亦无疼痛感。 此外,...
何女士,在医院查出一颗甲状腺良性肿瘤,平时触碰到会感觉刺痛,颈部有较强不适。
服用金康道夫天然水蛭素约一个月,她惊喜发现,甲状腺肿瘤明显缩小,已经感觉不到其存在,碰触该区域亦无疼痛感。

此外,何女士感觉现在的精神也比以前好很多,睡眠质素有很大提升,恭喜她,又一位因金康道夫天然水蛭素受益的有福之人!
相关新闻
- 2024-08-14身体出现这些表现,说明血管变硬了!
- 2024-08-13头部异响丨天然水蛭素改善20年头部不适
- 2024-08-12四高丨水蛭素受益者:「我不看广告宣传,只相信真实的人」
- 2024-08-09肝硬化、脂肪肝丨不吃药不打针,仅用一物阻断肝脏病变
- 2024-08-08血栓,伤人于无形之中!
- 2024-08-07「水蛭素」为何一定选金康道夫?
- 2024-08-06多靶点调理丨水蛭素同步多向调理心率不正、血压偏高、脂肪肝、肠胃等问题
- 2024-08-05骨刺、色斑丨水蛭素让身体由内而外焕发生机
- 2024-08-02颈动脉斑块不用怕,预防中风做好这4步!
- 2024-08-01水蛭素的真正价值,你了解吗?





 13902464931
13902464931